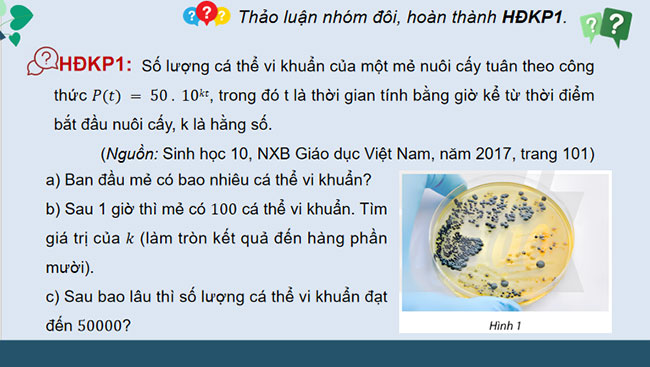
Phương trình bất phương trình mũ và lôgarit

Giáo án Toán 11 Bài 4: Phương trình bất phương trình mũ và lôgarit
Giáo án Toán 11 Bài 4: Phương trình bất phương trình mũ và lôgarit là tài liệu rất hữu ích được biên soạn dưới dạng PPT. Qua đó giúp quý thầy cô tiết kiệm thời gian làm bài giảng điện tử cho riêng mình.
Giáo án PowerPoint Toán 11 Bài 4: Phương trình bất phương trình mũ và lôgarit được thiết kế chi tiết, sinh động với nhiều hình ảnh đẹp mắt, giúp bài giảng trở nên hấp dẫn hơn. Qua giáo án PowerPoint Toán 11 Chương 6 Bài 4 giúp học sinh dễ tiếp thu, học nhanh và hiểu bài tốt hơn thông qua hình ảnh, sơ đồ, âm thanh. Vậy sau đây là nội dung chi tiết Giáo án PowerPoint Toán 11 Bài 4 Phương trình bất phương trình mũ và lôgarit Chân trời sáng tạo, mời các bạn tham khảo và tải tại đây nhé.
PowerPoint Toán 11 Bài 4: Phương trình bất phương trình mũ và lôgarit

..................
Mời các bạn tải file tài liệu để xem đầy đủ Giáo án PowerPoint Toán 11 Bài 4